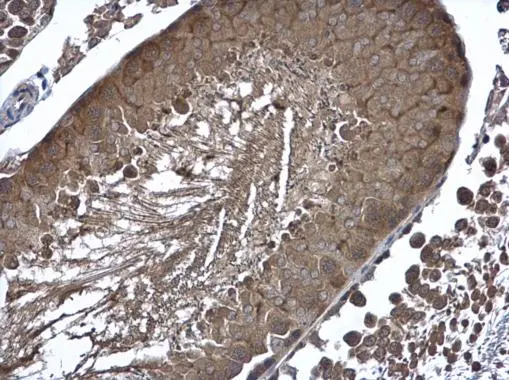
Cyclin B2 antibody detects Cyclin B2 protein at cytoplasm in rat testis by immunohistochemical analysis. Sample: Paraffin-embedded rat testis. Cyclin B2 antibody (GTX111118) diluted at 1:500. 
 Antigen Retrieval: Citrate buffer, pH 6.0, 15 min

![Cyclin B2 antibody [N1C3-2] detects CCNB2 protein at cytoplasm by immunofluorescent analysis. Sample: HeLa cells were fixed in ice-cold MeOH for 5 min. Green: CCNB2 protein stained by Cyclin B2 antibody [N1C3-2] (GTX111118) diluted at 1:500. Blue: Hoechst 33343 staining. Cyclin B2 antibody [N1C3-2] detects CCNB2 protein at cytoplasm by immunofluorescent analysis. Sample: HeLa cells were fixed in ice-cold MeOH for 5 min. Green: CCNB2 protein stained by Cyclin B2 antibody [N1C3-2] (GTX111118) diluted at 1:500. Blue: Hoechst 33343 staining.](https://www.genetex.com/upload/website/prouct_img/normal/GTX111118/GTX111118_40058_IFA_w_23060500_670.webp)
Cyclin B2 antibody [N1C3-2] detects CCNB2 protein at cytoplasm by immunofluorescent analysis. Sample: HeLa cells were fixed in ice-cold MeOH for 5 min. Green: CCNB2 protein stained by Cyclin B2 antibody [N1C3-2] (GTX111118) diluted at 1:500. Blue: Hoechst 33343 staining.
Cyclin B2 antibody
GTX111118
ApplicationsImmunoFluorescence, Western Blot, ImmunoCytoChemistry, ImmunoHistoChemistry, ImmunoHistoChemistry Paraffin
Product group Antibodies
ReactivityHuman, Rat
TargetCCNB2
Overview
- SupplierGeneTex
- Product NameCyclin B2 antibody
- Delivery Days Customer9
- Application Supplier NoteWB: 1:500-1:3000. ICC/IF: 1:100-1:1000. IHC-P: 1:100-1:1000. *Optimal dilutions/concentrations should be determined by the researcher.Not tested in other applications.
- ApplicationsImmunoFluorescence, Western Blot, ImmunoCytoChemistry, ImmunoHistoChemistry, ImmunoHistoChemistry Paraffin
- CertificationResearch Use Only
- ClonalityPolyclonal
- Concentration1 mg/ml
- ConjugateUnconjugated
- Gene ID9133
- Target nameCCNB2
- Target descriptioncyclin B2
- Target synonymsHsT17299, G2/mitotic-specific cyclin-B2
- HostRabbit
- IsotypeIgG
- Protein IDO95067
- Protein NameG2/mitotic-specific cyclin-B2
- Scientific DescriptionCyclin B2 is a member of the cyclin family, specifically the B-type cyclins. The B-type cyclins, B1 and B2, associate with p34cdc2 and are essential components of the cell cycle regulatory machinery. B1 and B2 differ in their subcellular localization. Cyclin B1 co-localizes with microtubules, whereas cyclin B2 is primarily associated with the Golgi region. Cyclin B2 also binds to transforming growth factor beta RII and thus cyclin B2/cdc2 may play a key role in transforming growth factor beta-mediated cell cycle control. [provided by RefSeq]
- ReactivityHuman, Rat
- Storage Instruction-20°C or -80°C,2°C to 8°C
- UNSPSC12352203